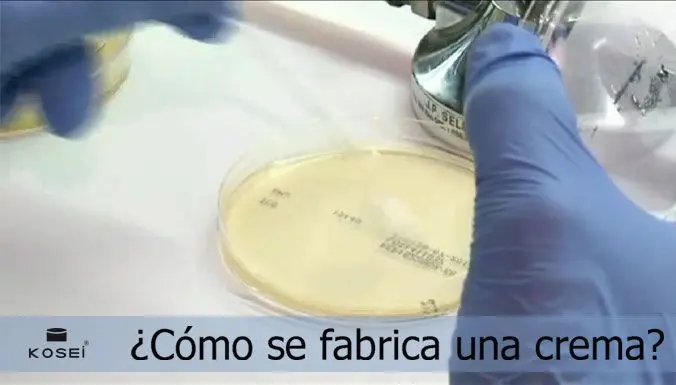
Curso Elaboración de Cremas: Guía Completa para Principiantes - Cómo se produce la crema curso elaboracion de cremas - Cómo se produce la crema

11/02/2018
¿Sueñas con crear tus propias cremas faciales y corporales? Aprende todo lo que necesitas saber sobre la elaboración de cremas artesanales con nuestro curso completo. Desde la selección de ingredientes hasta el envasado final, te guiaremos paso a paso para que puedas crear productos cosméticos naturales de alta calidad.
¿Qué aprenderás en nuestro curso?
Nuestro curso de elaboración de cremas cubre una amplia gama de temas esenciales, incluyendo:
- Selección de ingredientes: Aprenderás a identificar y seleccionar ingredientes naturales de alta calidad, como aceites vegetales, mantecas, ceras, y activos cosméticos.
- Propiedades de los ingredientes: Descubrirás las propiedades de cada ingrediente y cómo combinarlos para obtener cremas con diferentes texturas y beneficios para la piel.
- Formulación de cremas: Dominarás las técnicas de formulación para crear cremas hidratantes, nutritivas, antiedad, y para diferentes tipos de piel (seca, grasa, mixta, sensible).
- Métodos de elaboración: Aprenderás diferentes métodos de elaboración, como el método frío y el método caliente, adaptándote a las necesidades de cada fórmula.
- Conservación de cremas: Descubrirás la importancia de la conservación y cómo alargar la vida útil de tus cremas artesanales utilizando conservantes naturales y técnicas de almacenamiento adecuadas.
- Envasado y etiquetado: Aprenderás a envasar y etiquetar tus cremas de forma profesional, incluyendo información sobre la composición y caducidad.
- Seguridad y buenas prácticas: Te enseñaremos las medidas de higiene y seguridad necesarias para elaborar cremas en un entorno limpio y seguro.
Duración y Caducidad de las Cremas Artesanales
Una pregunta frecuente entre los amantes de la cosmética natural es la duración de sus cremas artesanales. A diferencia de las cremas comerciales, que suelen contener una gran cantidad de conservantes, las cremas artesanales tienen una vida útil más corta. La duración de una crema artesanal depende de varios factores, incluyendo:
- Ingredientes: Algunos ingredientes, como los aceites esenciales, son más propensos a la oxidación que otros.
- Método de elaboración: El método de elaboración influye en la estabilidad de la crema.
- Conservantes: El uso de conservantes naturales ayuda a prolongar la vida útil de la crema.
- Almacenamiento: Un almacenamiento adecuado, en un lugar fresco, oscuro y seco, es crucial para la conservación de la crema.
Generalmente, una crema artesanal, una vez abierta, puede durar entre 6 y 12 meses. Sin embargo, es importante observar cualquier cambio en su apariencia, olor o textura. Si notas algún cambio, deséchala. Nunca uses una crema después de su fecha de caducidad, incluso si parece estar en buen estado.
Tabla Comparativa: Cremas Artesanales vs. Cremas Comerciales
| Característica | Cremas Artesanales | Cremas Comerciales |
|---|---|---|
| Ingredientes | Naturales, sin parabenos ni siliconas | Pueden contener ingredientes sintéticos, parabenos, siliconas |
| Conservantes | Naturales o ausentes (vida útil más corta) | Sintéticos (vida útil más larga) |
| Duración | 6-12 meses una vez abierta | 2-4 años una vez abierta |
| Precio | Generalmente más caro | Generalmente más barato |
| Beneficios | Más beneficios para la piel, respetuoso con el medio ambiente | Más accesibles, mayor variedad |
Mitos y Realidades sobre las Cremas Naturales
Existen muchos mitos sobre las cremas naturales. Desmintamos algunos de ellos:
- Mito: Las cremas naturales no caducan. Realidad: Todas las cremas, incluso las naturales, caducan. Los ingredientes naturales son susceptibles a la degradación.
- Mito: Las cremas naturales no necesitan conservantes. Realidad: Para garantizar su seguridad y prolongar su vida útil, es recomendable usar conservantes naturales.
- Mito: Las cremas naturales duran más que las cremas convencionales. Realidad: Las cremas naturales, por lo general, tienen una vida útil más corta debido a la ausencia de conservantes sintéticos.
Consejos para Prolongar la Vida Útil de tus Cremas
- Almacenamiento: Guarda tus cremas en un lugar fresco, oscuro y seco, lejos de la luz solar directa y el calor.
- Higiene: Lava bien tus manos antes de manipular las cremas y utiliza utensilios limpios.
- Envases: Utiliza envases adecuados, preferentemente de vidrio oscuro o plástico opaco.
- Observación: Observa regularmente tus cremas en busca de cambios en su textura, olor o color. Si notas algo inusual, deséchala.
Consultas Habituales
¿Cómo puedo saber si una crema está en mal estado? Observa si presenta cambios en su textura, olor, color o si se separa.
¿Puedo reutilizar una crema que ha caducado? No, nunca reutilices una crema caducada para evitar posibles irritaciones o infecciones.
¿Qué conservantes naturales puedo usar? Algunos conservantes naturales comunes son el extracto de semilla de pomelo, el ácido benzoico y el ácido sórbico.
¿Dónde puedo comprar ingredientes para hacer cremas? Puedes encontrar ingredientes en tiendas de cosmética natural, herboristerías, y online.
Inscríbete en nuestro curso de elaboración de cremas y comienza a crear tus propios productos de belleza naturales. ¡Te esperamos!
Si quieres conocer otros artículos parecidos a Curso elaboración de cremas para principiantes puedes visitar la categoría Curso.

